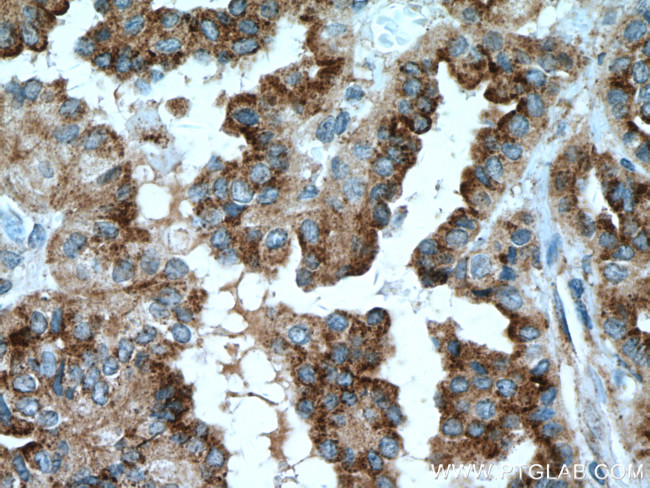
DIO2 Antibody in Immunohistochemistry (Paraffin) (IHC (P))

Search
Proteintech
DIO2 Monoclonal Antibody (1F2A1)
{{$productOrderCtrl.translations['antibody.pdp.commerceCard.promotion.promotions']}}
{{$productOrderCtrl.translations['antibody.pdp.commerceCard.promotion.viewpromo']}}
{{$productOrderCtrl.translations['antibody.pdp.commerceCard.promotion.promocode']}}: {{promo.promoCode}} {{promo.promoTitle}} {{promo.promoDescription}}. {{$productOrderCtrl.translations['antibody.pdp.commerceCard.promotion.learnmore']}}
产品信息
66813-1-IG
种属反应
宿主/亚型
分类
类型
克隆号
抗原
偶联物
形式
浓度
规格
纯化类型
保存液
内含物
保存条件
运输条件
产品详细信息
Aliquoting is unnecessary for -20°C storage.
靶标信息
The protein encoded by this gene belongs to the iodothyronine deiodinase family. It activates thyroid hormone by converting the prohormone thyroxine by outer ring deiodination to bioactive 3,3',5-triiodothyronine residues encoded by the UGA codon, which normally signals translation termination. The 3' UTR of Sec-containing genes have a common stem-loop structure, the sec insertion sequence, which is necessary for the recognition of UGA as a Sec codon rather than as a stop signal. Alternative splicing results in multiple transcript variants encoding different isoforms.
仅用于科研。不用于诊断过程。未经明确授权不得转售。
生物信息学
蛋白别名: 5DII; deiodinase, iodothyronine type II; deiodinase-2; deiodonase-2; DIOII; selenoprotein Y; thyroxine deiodinase; thyroxine deiodinase, type II; thyroxine type II; Type 2 DI; type 2 iodothyronine deiodinase; Type II iodothyronine deiodinase; Type-II 5'-deiodinase; type-II 5'deiodinase; unnamed protein product
基因别名: 5DII; D2; DIO2; DIOII; ITDI2; SELENOY; SelY; TXDI2
UniProt ID: (Human) Q92813
Entrez Gene ID: (Human) 1734